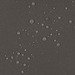

Tissu déperlant - Uni
Otter Brown - 50 cm x 140 cm
Code d'article: 740-C035-10-50
Canvas polyester imperméable – robuste et léger.
Description du produit
Toile polyester robuste et légère avec envers déperlant — idéale pour des sacs résistants à la pluie.
Durable, stable et flexible. Convient aux sacs à dos, cabas et accessoires.
Facile à coudre avec une machine domestique (conseil : utilisez une aiguille Microtex).
Lavage en machine à 30°C, repassage à basse température.
Convient pour doublures et extérieurs — un tissu qui allie style et fonctionnalité.